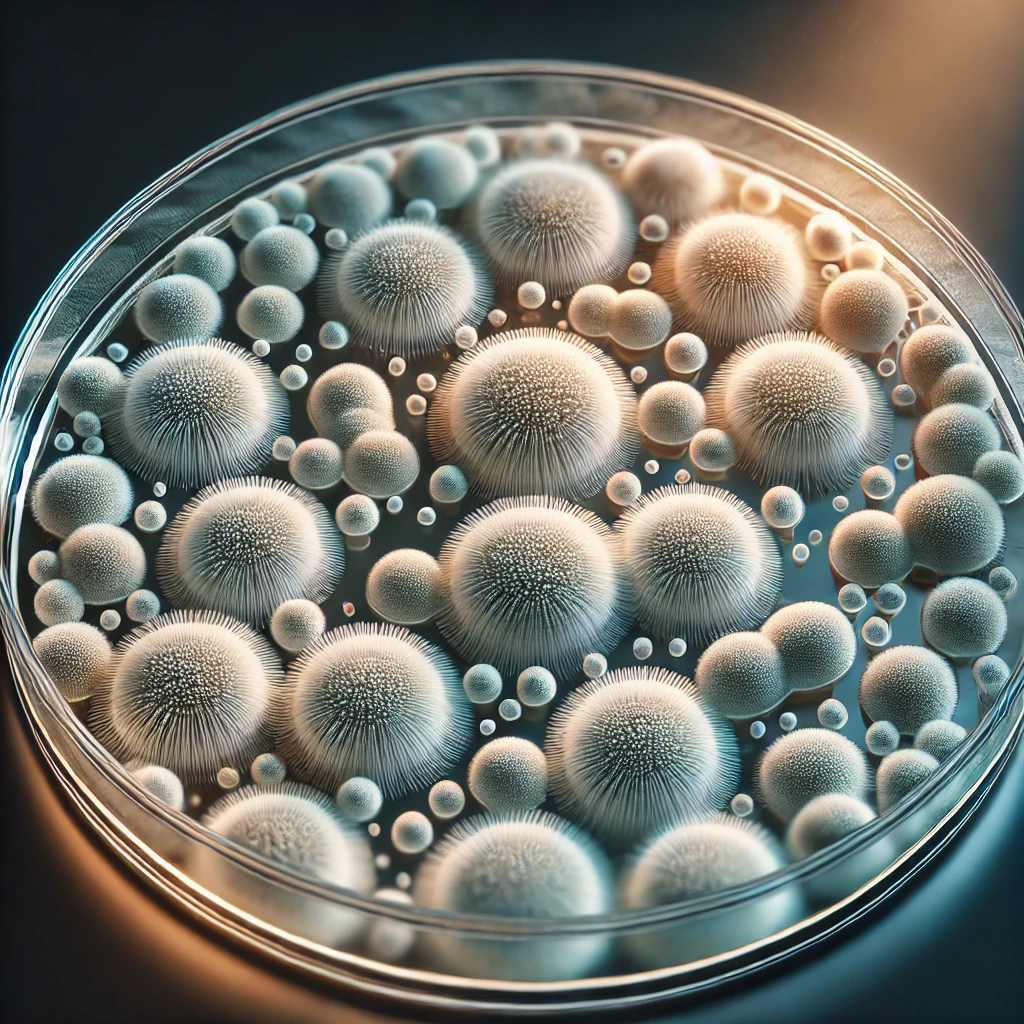
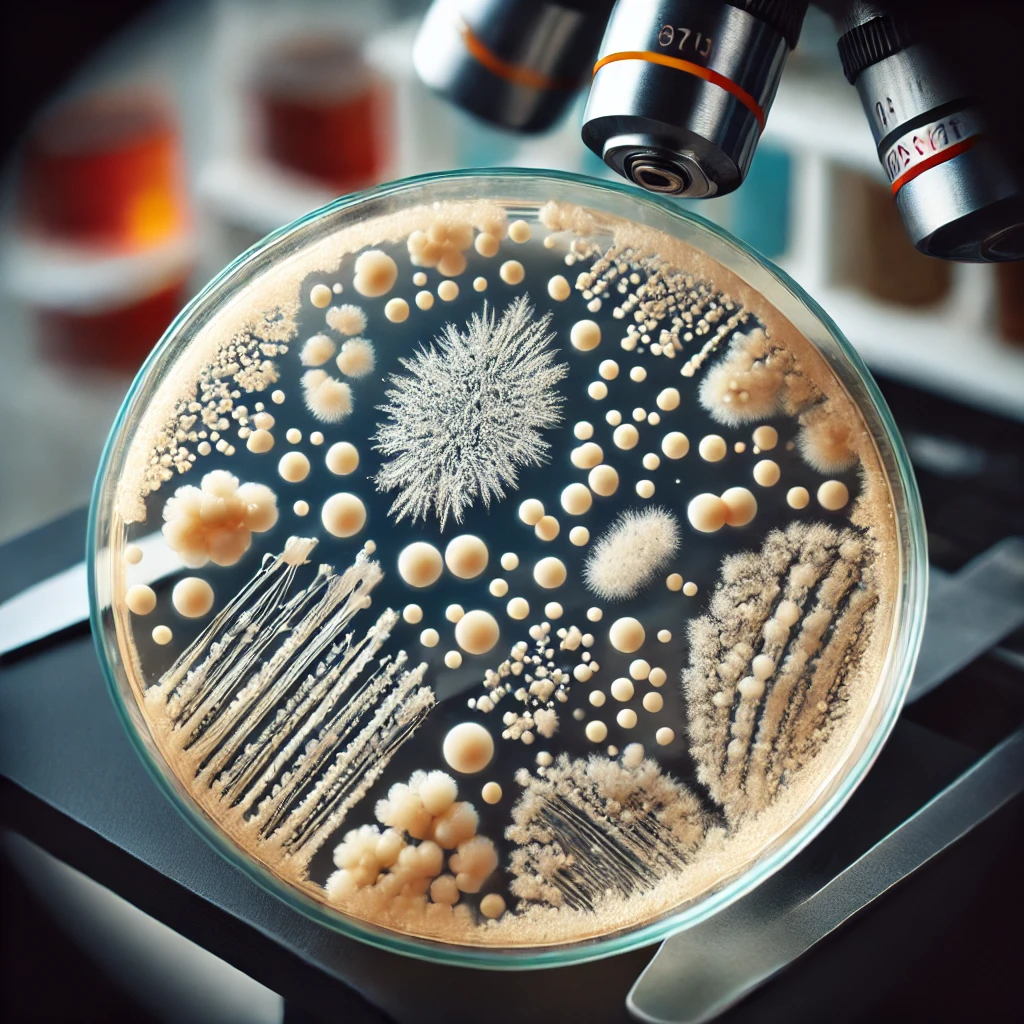

티스토리 뷰
목차
낙산균 vs 유산균: 정말 장 건강에 좋은 것은?

여러분들은 장 건강을 위협받고 있으시지는 않나요?
현대인의 식습관과 스트레스로 인해 장 건강이 악화되고 있습니다.
많은 사람들이 유산균을 찾지만, 유산균만으로 해결되지 않는 문제가 있다는 사실, 알고 계셨나요?
바로 ‘낙산균’입니다. 낙산균은 장 점막을 보호하고, 장 건강을 근본적으로 개선하는 데 중요한 역할을 합니다.
그렇다면 유산균과 낙산균의 차이점은 무엇이며, 어떤 균이 장 건강에 더 효과적일까요?
지금부터 유산균 낙산균의 차이, 효과, 부작용 및 FAQ(자주하는 질문)에 대해 자세히 알아보겠습니다.
1. 낙산균과 유산균의 차이점



낙산균과 유산균은 모두 장내 유익균으로 알려져 있지만, 기능과 역할에 있어 차이가 큽니다.
| 구 분 | 유 산 균 | 낙 산 균 |
| 정의 | 장내 환경을 산성으로 만들어 유해균 억제 | 단쇄 지방산(낙산)을 생성하여 장 점막 보호 |
| 주요 기능 | 유익균 증식, 소화 촉진, 면역력 강화 | 장 점막 재생, 염증 완화, 장누수 예방 |
| 생존력 | 위산과 담즙산에 취약하여 장까지 도달 어려움 | 장내에서 안정적으로 정착 가능 |
| 대표 균주 | 락토바실러스, 비피도박테리움 등 | 클로스트리디움 뷰티리쿰 등 |
유산균은 장내 유익균 비율을 높이는 역할을 하지만, 위산과 담즙산에 의해 쉽게 사멸할 수 있습니다.
반면, 낙산균은 장에서 직접 낙산(Butyrate)을 생성하여 장 점막을 보호하고 장 기능을 근본적으로 개선하는 역할을 합니다.
2. 낙산균의 효과



낙산균은 단순히 유익균을 늘리는 것을 넘어, 장 건강을 근본적으로 개선하는 다양한 효과를 가지고 있습니다.
점막 보호 및 장누수 증후군 예방
낙산은 장 점막 세포의 주요 에너지원으로 작용하여, 장 점막을 튼튼하게 유지하고 손상을 방지합니다.
이는 ‘장누수 증후군(Leaky Gut Syndrome)’을 예방하는 데 중요한 역할을 합니다.
염증 억제 및 면역력 강화
낙산균은 장내 염증을 줄이고 면역 기능을 강화하는 데 도움을 줍니다.
이는 크론병, 궤양성 대장염과 같은 염증성 장질환 예방에도 기여할 수 있습니다.
변비 및 설사 개선
낙산균은 장운동을 조절하여 변비와 설사 증상을 완화하는 데 도움을 줄 수 있습니다.
특히, 과민성 대장증후군(IBS) 환자들에게 긍정적인 효과를 보인다는 연구 결과도 있습니다.
대장암 예방 가능성
낙산은 장내에서 항암 효과를 나타내는 것으로 알려져 있습니다.
대장암 세포의 성장을 억제하고 정상적인 세포 재생을 촉진하여 대장암 예방에 기여할 가능성이 있습니다.
3. 낙산균의 부작용 및 주의사항



아무리 좋은 균이라도 무조건 섭취하는 것이 정답은 아닙니다. 낙산균을 섭취할 때 주의해야 할 몇 가지 사항이 있습니다.
- 초기 복통 및 가스 발생: 장내 환경이 적응하는 과정에서 일시적으로 가스가 차거나 복통이 생길 수 있습니다.
- 과다 섭취 시 설사 유발: 과도한 낙산이 장 운동을 지나치게 활성화할 수 있어 설사를 유발할 수 있습니다.
- 특정 질환 환자의 주의 필요: 크론병이나 과민성 대장증후군(IBS) 환자는 전문의와 상담 후 섭취하는 것이 좋습니다.
그렇다면 유산균과 낙산균, 어떤 균이 더 중요할까?



유산균이 장내 유익균을 늘리고 소화 기능을 돕는다면, 낙산균은 장 점막을 보호하고 면역력을 강화하는 역할을 합니다.
단순히 ‘어떤 균이 더 좋다’라고 말하기보다는, 유산균과 낙산균을 함께 섭취하여 장 건강을 더욱 강화하는 것이 최상의 방법이라고 할 수 있습니다.
장 건강을 개선하고 싶다면 유산균뿐만 아니라, 낙산균 섭취도 함께 고려해 보세요. 장을 튼튼하게 유지하는 것이 결국 건강한 삶의 시작입니다!
FAQ (자주 묻는 질문)



Q1. 낙산균과 유산균을 함께 먹어도 되나요?
A. 네, 함께 섭취하면 상호 보완적인 효과를 얻을 수 있습니다.
Q2. 낙산균은 어디서 얻을 수 있나요?
A. 낙산균은 보충제 형태로 판매되며, 일부 발효 식품에서도 소량 포함되어 있습니다.
Q3. 낙산균은 누구에게 추천하나요?
A. 장 건강이 약한 사람, 변비·설사로 고민하는 사람, 장누수 증후군을 예방하고 싶은 사람에게 추천합니다.
장 건강을 위해 지금부터라도 낙산균에 대한 관심을 가져보세요!





